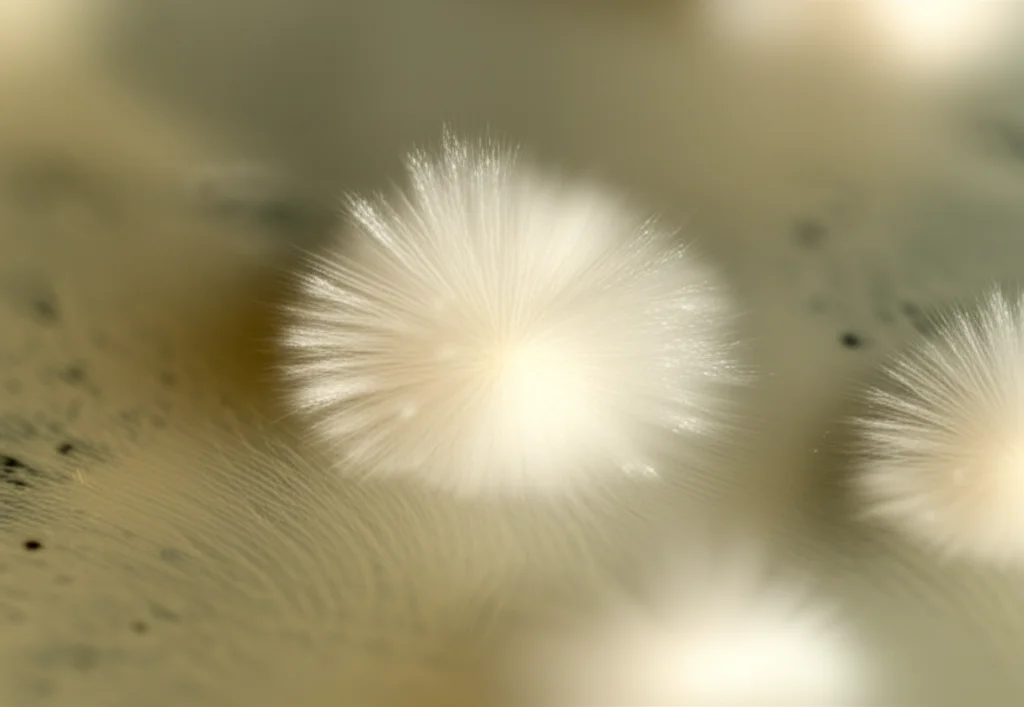
Macro fotografia di una coltura del fungo filamentoso Amylomyces rouxii in una piastra di Petri trasparente, obiettivo macro 100mm, alta definizione dei dettagli delle ife bianche e cotonose, illuminazione controllata da laboratorio che crea ombre morbide, sfondo sfocato.

Tirosinasi Superpotenziata: Il Segreto Nascosto in un Fungo Modificato!
Ciao a tutti, appassionati di scienza e scoperte! Oggi voglio portarvi con me in un viaggio affascinante nel mondo microscopico dei funghi e dei loro incredibili enzimi. Parleremo di un enzima particolare, la tirosinasi, e di come un team di scienziati sia riuscito a “potenziarlo” lavorando su un fungo un po’ speciale, l’Amylomyces rouxii. Pronti a scoprire come hanno fatto?
Un Enzima dai Due Volti: Ecco la Tirosinasi
Prima di tutto, cos’è questa tirosinasi (o polifenolossidasi, se preferite il nome più tecnico)? Immaginate un operaio specializzato nel nostro corpo o in altri organismi, appartenente alla grande famiglia delle proteine contenenti rame (tipo 3, per i più precisi). Questo enzima è un vero trasformista: catalizza ben due reazioni consecutive, usando ossigeno molecolare.
- Prima, si occupa dell’o-idrossilazione dei monofenoli (questa è la sua attività monofenolasica). È una reazione un po’ più lenta a partire.
- Poi, passa all’azione ossidando gli o-difenoli per creare o-chinoni reattivi (attività difenolasica). Questa seconda fase è solitamente più sprint.
Dove la troviamo? Praticamente ovunque! Mammiferi (noi compresi, è fondamentale per produrre la melanina!), invertebrati, piante (è la “colpevole” dell’imbrunimento di frutta e verdura tagliata come mele e patate) e, ovviamente, microrganismi come batteri e funghi. Nei funghi filamentosi, ad esempio, partecipa alla creazione dei pigmenti delle spore.
Il Problema: Un Fungo Utile ma… Autolesionista?
Il nostro protagonista fungino è l’Amylomyces rouxii, un zigomicete isolato originariamente da acque reflue di una cartiera (già questo ci dice che è un tipo tosto!). La cosa interessante è che questo fungo produce tirosinasi e la rilascia anche all’esterno delle sue cellule (tirosinasi extracellulare). Questo è un gran vantaggio! Pensateci: ottenere enzimi dall’interno delle cellule richiede di romperle, un processo che può essere complicato e ridurre la resa. Avere un enzima già “fuori” è molto più comodo, specialmente per applicazioni come la bonifica ambientale (bioremediation), dove l’enzima deve agire su composti presenti nell’ambiente.
Ma ecco l’inghippo: l’A. rouxii, oltre alla preziosa tirosinasi, produce anche una proteasi aspartica extracellulare. Le proteasi sono enzimi che “tagliano” altre proteine. In pratica, il nostro fungo produceva un enzima utile e, contemporaneamente, un altro enzima che lo degradava! Un po’ come costruire un castello di sabbia mentre le onde lo portano via. Tentativi precedenti di purificare la tirosinasi da questo fungo, infatti, non avevano avuto successo proprio per questo motivo. Frustrante, vero?
La Soluzione Geniale: Silenziare il “Sabotatore”
Ed è qui che entra in gioco l’ingegneria genetica! I ricercatori hanno pensato: “E se riuscissimo a zittire il gene che produce quella fastidiosa proteasi?”. Detto, fatto! Utilizzando una tecnica chiamata interferenza dell’RNA (RNAi), hanno “silenziato” il gene responsabile della produzione della proteasi aspartica II nel fungo. Hanno così creato un ceppo mutante, chiamato A412-3.
Questo ceppo trasformato ha mostrato esattamente quello che si sperava: un’attività proteasica ridotta e, di conseguenza, un’attività tirosinasica decisamente più elevata rispetto al ceppo originale (“parentale”). I risultati sono stati notevoli: nel ceppo A412-3, l’attività monofenolasica extracellulare è aumentata di 2,14 volte e quella difenolasica addirittura di 3,02 volte! Un successo su tutta la linea. Hanno anche confermato che l’enzima secreto era già nella sua forma attiva.
Alla Ricerca dell’Enzima Potenziato: Purificazione e Caratterizzazione
Ora che avevano un ceppo “superproduttore” di tirosinasi stabile, il passo successivo era isolare e purificare questo enzima extracellulare potenziato. Non è un’impresa facile, perché i funghi producono un sacco di altre proteine ed enzimi (laccasi, chinone reduttasi, ecc.) che possono “contaminare” l’estratto.
Il team ha prelevato il brodo di coltura del ceppo A412-3 dopo 48 ore (il momento di massima produzione dell’enzima), ha rimosso le cellule fungine e ha iniziato il processo di purificazione. Hanno usato tecniche classiche ma efficaci:
- Precipitazione: Hanno concentrato le proteine usando solfato d’ammonio.
- Dialisi: Hanno rimosso i sali in eccesso.
- Cromatografia: Hanno separato le proteine prima con una colonna a scambio anionico (DEAE-Sepharose) e poi con una colonna di filtrazione su gel (Sephadex-200).
Alla fine di questo processo, sono riusciti a ottenere una preparazione di tirosinasi parzialmente purificata, con un fattore di purificazione di 10,6 volte rispetto all’estratto grezzo. Non male!

Cosa Ci Dice l’Analisi?
Ma com’è fatto questo enzima purificato? Per scoprirlo, hanno usato altre tecniche:
- SDS-PAGE: Una sorta di “corsa a ostacoli” per le proteine su un gel, che le separa in base alla loro dimensione (peso molecolare). Questa analisi ha rivelato tre bande principali con pesi molecolari apparenti di circa 40, 53 e 130 kDa (kiloDalton). La banda a 40 kDa era particolarmente interessante.
- Focalizzazione isoelettrica: Hanno determinato il punto isoelettrico (pI) dell’enzima, che è risultato essere intorno a 5.2, un valore in linea con altre tirosinasi fungine che spesso esistono in diverse isoforme (versioni leggermente diverse dello stesso enzima).
- Sequenziamento LC-MS/MS: Hanno “tagliato” le proteine delle bande separate su gel in piccoli pezzi (peptidi) e ne hanno analizzato la sequenza di amminoacidi tramite spettrometria di massa. Bingo! Analizzando la banda da 40 kDa, hanno identificato otto peptidi che mostravano una forte somiglianza con le sequenze di tirosinasi di altri funghi, in particolare quella di Agaricus bisporus (il comune fungo champignon).

Una delle sequenze peptidiche identificate (la numero 4) conteneva addirittura la sequenza QXXG(I/V)HGXP. Quella “H” (istidina) è cruciale: fa parte del sito di legame CuA, una regione altamente conservata nelle tirosinasi fungine, fondamentale per legare uno dei due atomi di rame necessari all’attività dell’enzima. Questa è stata la conferma definitiva: la proteina extracellulare prodotta da A. rouxii A412-3 è proprio una tirosinasi, con un peso molecolare intorno ai 40-45 kDa, simile a molte altre tirosinasi fungine conosciute.
Perché Tutto Questo è Importante?
Questa ricerca è significativa per diversi motivi. Innanzitutto, dimostra che è possibile superare il problema dell’autodegradazione della tirosinasi in A. rouxii silenziando il gene della proteasi, ottenendo così rese molto più alte di enzima attivo extracellulare. Questo apre la porta a una produzione più efficiente di tirosinasi da questa fonte.
In secondo luogo, avere a disposizione più tirosinasi extracellulare potrebbe migliorare la sua efficacia in applicazioni pratiche, come la degradazione di composti fenolici tossici in acque reflue o terreni contaminati. L’enzima extracellulare non ha bisogno che i contaminanti entrino nella cellula fungina per agire.
Infine, questo studio aggiunge un tassello importante alla nostra conoscenza delle tirosinasi fungine, studiando in dettaglio un enzima proveniente da uno zigomicete, un gruppo di funghi meno studiato per questo enzima rispetto agli ascomiceti (come Aspergillus, Trichoderma) o ai basidiomiceti (come Agaricus). È la prima volta che una tirosinasi da uno zigomicete viene purificata parzialmente e sequenziata a livello peptidico.
Insomma, silenziando un gene “fastidioso”, abbiamo sbloccato il potenziale di un fungo per produrre un enzima prezioso in quantità maggiori e in forma più accessibile. Un bell’esempio di come la comprensione della biologia fondamentale e l’ingegneria genetica possano portare a soluzioni innovative con applicazioni biotecnologiche concrete! Chissà quali altre meraviglie si nascondono nel regno dei funghi…

Fonte: Springer







